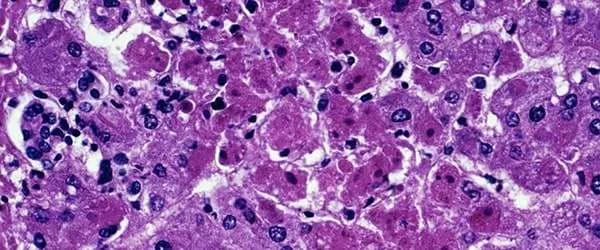

Bài Mới nhất

FDA cảnh báo loạt siêu thị vẫn bán sữa gây ngộ độc botulinum
(TAP) - Vừa qua, Cục Quản lý Thực phẩm và Dược phẩm Hoa Kỳ (FDA) gửi thư cảnh báo hàng loạt chuỗi bán lẻ tại Hoa Kỳ vẫn bày bán sữa công thức cho trẻ sơ sinh ByHeart Whole Nutrition - sản phẩm đã bị thu hồi trên toàn quốc vì gây nhiều ca ngộ độc Botulinum.

WHO khẳng định vắc xin không gây ra chứng tự kỷ
(TAP) - Tổ chức Y tế thế giới (WHO) vừa tái khẳng định lập trường vắc xin không gây ra chứng tự kỷ. Đây là kết quả nghiên cứu mới nhất do Ủy ban Tư vấn toàn cầu về an toàn vắc xin (GACVS) công bố dựa trên bằng chứng hiện có.

Công nghệ in 3D FITme - “Làn sóng” mới trong Phẫu thuật Thẩm mỹ hiện nay
(TAP) - Sự trỗi dậy của công nghệ mô phỏng và máy móc tự động hóa đang tạo ra một cuộc cách mạng trong mọi lĩnh vực đời sống, từ y tế, sản xuất đến dịch vụ. Trong đó, lĩnh vực phẫu thuật thẩm mỹ đã chứng kiến những bước tiến đáng kể nhất. Việc ứng dụng công nghệ in 3D không chỉ dừng lại ở việc hỗ trợ chẩn đoán mà đã tham gia sâu vào quá trình thiết kế vật liệu cấy ghép, mang đến độ chính xác và tính cá nhân hóa vượt trội.

Việt Nam nỗ lực chấm dứt HIV/AIDS
(TAP) - Việt Nam đang đẩy mạnh các giải pháp phòng, chống HIV/AIDS trong bối cảnh số ca nhiễm mới còn cao và nhiều thách thức kéo dài. Mở rộng các biện pháp dự phòng, bảo đảm điều trị không gián đoạn, giảm kỳ thị với người nhiễm được coi là những yếu tố quyết định để Việt Nam tiến gần mục tiêu chấm dứt HIV/AIDS vào năm 2030.

WHO: Số ca mắc sởi toàn cầu tăng trở lại
(TAP) - Tổ chức Y tế Thế giới (WHO) cho biết số ca mắc sởi đang tăng lên trên toàn cầu, trong khi số ca tử vong do bệnh này tiếp tục giảm. Đặc biệt ở Hoa Kỳ, giữa bối cảnh tỷ lệ tiêm chủng trẻ em giảm và tâm lý hoài nghi vaccine gia tăng, giới chức y tế nước này gần đây ghi nhận số ca mắc sởi đạt mức cao nhất kể từ năm 2000.

WHO tuyên bố chấm dứt đợt bùng phát virus gây bại liệt ở Indonesia
(TAP) - Tổ chức Y tế Thế giới (WHO) thông báo, đợt bùng phát virus gây bại liệt tại Indonesia chính thức kết thúc sau gần 3 năm nỗ lực kiểm soát. Thông tin xuất hiện sau khi WHO xác nhận không còn virus lây lan ở trẻ em hoặc trong môi trường sống kể từ tháng 6/2024.

Việt Nam: Trẻ em được tiêm miễn phí vaccine Rota từ 2026
(TAP) - Tại Việt Nam, từ năm 2026, trẻ em sẽ được uống miễn phí vaccine Rota, tiêm HPV và tiếp tục tiếp cận vaccine phế cầu theo lộ trình mở rộng. Đây là bước tiến trong kế hoạch đưa các vaccine mới vào Chương trình tiêm chủng mở rộng giai đoạn 2021-2030.

Việt Nam: Thu hồi loạt kem chống nắng giả
(TAP) - Cục Quản lý Dược (Bộ Y tế Việt Nam), vừa đình chỉ lưu hành, thu hồi kem chống nắng LYZEEN SPF50+ PA++++ và Gel Panda Baby Bạch Liên. Kết quả kiểm nghiệm kem chống nắng LYZEEN là “hàng giả” có chỉ số SPF thấp hơn 70% so với công bố, trong khi Gel Panda Baby không đạt giới hạn vi sinh vật, tiềm ẩn nguy cơ cho người tiêu dùng.

Bộ Y tế yêu cầu điều tra vụ ngộ độc bánh mì tại TP. HCM
(TAP) - Liên quan đến vụ hàng trăm người bị ngộ độc thực phẩm do ăn bánh mì, Bộ Y tế Việt Nam vừa yêu cầu tổ chức điều tra, truy xuất nguồn gốc thực phẩm và xử lý nghiêm vi phạm (nếu có).

Tỏi - Thần dược phòng ngừa ung thư
(TAP) - Tỏi từ lâu đã được biết đến không chỉ là một loại gia vị phổ biến khi nấu ăn mà còn là một “thần dược” ở lĩnh vực y học. Ngày nay, nhiều nghiên cứu hiện đại đã chỉ ra rằng tỏi có tiềm năng lớn phòng ngừa ung thư, nhờ vào những hợp chất đặc biệt có trong loại củ này.

FDA hạn chế bán sản phẩm chứa fluoride chưa phê duyệt cho trẻ
(TAP) - Cục Quản lý Thực phẩm và Dược phẩm Hoa Kỳ (FDA) mới đây đã công bố các biện pháp nhằm hạn chế việc bán, sử dụng sản phẩm chứa fluoride chưa được phê duyệt cho trẻ em. Bộ trưởng Bộ Y tế và Dịch vụ Nhân sinh (HHS) Robert F. Kennedy Jr tuyên bố, quyết định trên thể hiện nỗ lực từ Chính phủ trong việc bảo vệ sức khỏe nhóm dễ bị tổn thương, cần ưu tiên bảo vệ.

Hoa Kỳ: Tỷ lệ béo phì giảm nhưng tỷ lệ tiểu đường cao kỷ lục
(TAP) - Tỷ lệ béo phì tại Hoa Kỳ đang có dấu hiệu giảm suốt 3 năm qua - trùng với thời điểm ngày càng nhiều người sử dụng thuốc giảm cân chứa hoạt chất GLP-1. Mặc dù vậy, số người mắc bệnh tiểu đường, dựa trên chẩn đoán từ bác sĩ năm 2024, vẫn đạt mức cao kỷ lục.

FDA Thái Lan cảnh báo dầu hít Hong Thai nhiễm vi sinh
(TAP) - Mới đây, Cục Quản lý Thực phẩm và Dược phẩm Thái Lan (FDA) đã công bố kết quả kiểm tra dầu hít mũi Hong Thai, phát hiện sản phẩm vi phạm tiêu chuẩn kỹ thuật và nhiễm khuẩn vượt mức quy định. Do đó, cơ quan phát cảnh báo để người tiêu dùng ngưng sử dụng.

Lá húng chanh - Thảo dược dân gian trị ho, giải cảm, tăng cường sức khỏe
(TAP) - Lá húng chanh, còn gọi là tần dày lá hay dương tử tô, là thảo dược dân gian quen thuộc, thường xuất hiện trong bữa cơm gia đình như rau gia vị và được xem là vị thuốc quý. Nhờ chứa nhiều hoạt chất có lợi, húng chanh giúp cơ thể kháng khuẩn, giảm viêm, tiêu đờm, trị ho, giải cảm và tăng cường sức đề kháng tự nhiên.

Thuốc tiêm ngừa HIV sắp được triển khai ở nhiều quốc gia
(TAP) - Lenacapavir là một loại thuốc ngăn ngừa lây nhiễm HIV tiên tiến nhất hiện nay, đạt hiệu quả gần 100% qua nhiều thử nghiệm. Nó sắp được triển khai tại Zimbabwe và nhiều quốc gia châu Phi.

Cây chùm bao: Vị thuốc quý từ thiên nhiên
(TAP) - Trong kho tàng dược liệu Việt Nam, cây chùm bao (hay cây lạc tiên, dây nhãn lồng) từ lâu được sử dụng như loài thảo mộc dân dã ẩn chứa nhiều giá trị y học quý báu. Loại cây này không chỉ là bài thuốc giúp con người tìm lại giấc ngủ an yên mà còn hỗ trợ tinh thần thư thái giữa nhịp sống hiện đại.

WHO: Bệnh lý thần kinh gây hơn 11 triệu ca tử vong mỗi năm
(TAP) - Tổ chức Y tế Thế giới (WHO) mới đây phát đi cảnh báo các quốc gia cần tăng cường đầu tư và chăm sóc bệnh lý liên quan đến thần kinh. WHO nhấn mạnh đây là nhóm bệnh gây ra hơn 11 triệu ca tử vong mỗi năm, ảnh hưởng đến hơn 3 tỷ người, tương đương 40% dân số toàn cầu.

WHO cảnh báo sự lây lan nhanh chóng của siêu vi khuẩn kháng thuốc
(TAP) - Tổ chức Y tế Thế giới (WHO) vừa đưa ra cảnh báo về tốc độ lây lan đáng lo ngại của các siêu vi khuẩn kháng thuốc. WHO quan ngại, diễn biến này trở thành một trong những mối đe dọa sức khỏe nghiêm trọng nhất đối với nhân loại.

Số ca ung thư tiểu thuỳ xâm lấn: Tăng nhanh gấp ba lần so với loại ung thư vú khác
(TAP) - Báo cáo mới từ Hiệp hội Ung thư Hoa Kỳ (ACS) cho thấy, ung thư tiểu thùy xâm lấn - loại ung thư vú khó phát hiện chiếm hơn 10% tổng số ca tại Hoa Kỳ. Ghi nhận dạng bệnh ác tính này tăng nhanh khoảng 3% mỗi năm, cao gấp ba lần so với những loại ung thư vú khác.

Mùa mưa lũ: Cảnh báo nguy cơ bệnh xoắn khuẩn vàng da
(TAP) - Mùa mưa bão không chỉ gây lũ lụt, ngập úng mà còn làm gia tăng nguy cơ mắc nhiều bệnh truyền nhiễm, trong đó có bệnh xoắn khuẩn vàng da (Leptospirosis). Tổ chức Y tế Thế giới (WHO) và các cơ quan y tế Việt Nam cảnh báo rằng bệnh có thể xảy ra tại mọi vùng miền, đặc biệt ở những người phải tiếp xúc trực tiếp với nước lũ hoặc đất nhiễm khuẩn.

WHO cảnh báo tình trạng gia tăng siêu vi khuẩn kháng kháng sinh
(TAP) - Ngày 2/10, Tổ chức Y tế Thế giới (WHO) công bố các báo cáo cho thấy tình trạng gia tăng đáng lo ngại của vi khuẩn kháng kháng sinh trên toàn cầu. Giữa bối cảnh đó, công cụ chẩn đoán và phương pháp điều trị đều không đủ đáp ứng để điều trị tình trạng này.

Sắp mở bán thuốc tiêm ngừa HIV với giá 1 triệu đồng/năm
(TAP) - Tổ chức Y tế quốc tế (Unitaid) vừa công bố kế hoạch phổ biến loại thuốc tiêm lenacapavir - biện pháp phòng ngừa HIV, tại hơn 100 quốc gia trên thế giới, trong đó có Việt Nam. Dự kiến, thuốc sẽ được bán với giá 40 USD mỗi năm (tương đương 1 triệu đồng) kể từ năm 2027.

EU bác bỏ cảnh báo của Trump về mối liên hệ giữa paracetamol và chứng tự kỷ
(TAP) - Cơ quan Dược phẩm Châu Âu (EMA) thuộc EU vừa phản hồi phát ngôn gây tranh cãi của Tổng thống Donald Trump liên quan đến việc sử dụng thuốc giảm đau paracetamol trong thai kỳ có nguy cơ khiến trẻ sau sinh mắc chứng tự kỷ. EMA khẳng định chưa có bằng chứng khoa học nào chứng minh mức độ gây hại như lãnh đạo Nhà Trắng cảnh báo.

Việt Nam: Nhiều ca tử vong do bệnh dại vì chủ quan không tiêm vaccine
(TAP) - Tính riêng 9 tháng đầu năm 2025, Việt Nam ghi nhận 58 ca tử vong do bệnh dại tại 18 tỉnh, thành phố. Đáng chú ý, đa số các trường hợp tử vong đều do không tiêm vaccine hoặc huyết thanh kháng dại. Trong đó, nguyên nhân chính là người dân chủ quan nghĩ rằng chó nhà cắn không nguy hiểm.

Khủng hoảng thiếu thuốc đang kéo dài tại EU
(TAP) - Cuộc khủng hoảng thiếu thuốc đang kéo dài tại Liên minh Châu Âu (EU), với ít nhất 34 loại thuốc khan hiếm. Nguyên nhân chính đến từ sự phân mảnh và thiếu ràng buộc pháp lý trong hệ thống giám sát dược phẩm toàn khối.

Từ năm 2026, người dân được khám sức khỏe miễn phí định kỳ hằng năm
(TAP) – Theo Nghị quyết 72-NQ/TW của Bộ Chính trị Việt Nam, từ năm 2026, toàn dân sẽ khám sức khỏe định kỳ hoặc sàng lọc miễn phí ít nhất mỗi năm một lần. Đến năm 2030, người dân hưởng chính sách miễn viện phí cơ bản trong phạm vi quyền lợi bảo hiểm y tế, hướng tới mục tiêu chăm sóc sức khỏe toàn dân công bằng, bền vững.

Tỷ lệ tử vong ở Hoa Kỳ giảm gần 4% vào năm 2024 nhờ COVID-19?
(TAP) - Theo Trung tâm Kiểm soát và Phòng ngừa Dịch bệnh (CDC), tỷ lệ tử vong chung ở Hoa Kỳ giảm gần 4% vào năm 2024. Sự suy giảm này có liên quan trực tiếp đến việc COVID-19 không còn nằm trong top 10 nguyên nhân gây tử vong hàng đầu kể từ năm 2020.

Bệnh Chagas: Mối nguy hiểm từ “bọ hôn” có dấu hiệu lan rộng tại Hoa Kỳ
(TAP) - Còn được gọi bằng cái tên bệnh “bọ hôn”, Chagas là căn bệnh nguy hiểm do ký sinh trùng gây ra vốn phổ biến tại 21 quốc gia châu Mỹ, nhưng đang có dấu hiệu lan rộng tại Hoa Kỳ.

WHO cảnh báo hai dịch bệnh nguy hiểm
(TAP) - Tổ chức Y tế Thế giới (World Health Organization, viết tắt: WHO) mới đây (ngày 3/9) phát đi cảnh báo toàn cầu về hai dịch bệnh nguy hiểm, bao gồm bệnh chảy máu mắt ở người do virus Marburg và bệnh tả.

Đu đủ - Trái cây quen thuộc sở hữu nhiều lợi ích tuyệt vời cho sức khỏe
(TAP) - Đu đủ không chỉ là loại quả phổ biến, giá rẻ mà còn chứa nhiều dưỡng chất quý giá; giúp cải thiện tiêu hóa, tăng cường miễn dịch, làm đẹp da và hỗ trợ phòng ngừa nhiều bệnh lý nguy hiểm.

Lợi ích sức khỏe từ lá tía tô
(TAP) - Lá tía tô hay tử tô (tên khoa học: Perilla frutescens) là loài cây thân thảo thuộc họ Hoa môi (Lamiaceae), có mùi thơm đặc trưng, vị cay, tính ấm, thường xuyên xuất hiện trong bữa ăn của người Việt. Tuy nhiên, ít ai biết rằng, tía tô còn được ví như một vị thuốc quý mang đến nhiều lợi ích cho sức khỏe con người.

Cải bó xôi – Thực phẩm mang nhiều lợi ích cho sức khỏe
(TAP) - Cải bó xôi hay rau chân vịt (spinach) là một loại rau lá xanh đậm có nguồn gốc từ Ba Tư, được biết đến rộng rãi trên toàn thế giới nhờ hàm lượng dinh dưỡng vượt trội và mang nhiều lợi ích cho sức khỏe.

Đậu bắp – Thực phẩm vàng cho sức khỏe
(TAP) - Đậu bắp là một thực phẩm quen thuộc trong bữa ăn của nhiều gia đình Việt. Không chỉ giàu giá trị dinh dưỡng, loại quả này còn mang lại nhiều lợi ích cho sức khỏe.

Sức khỏe tâm thần: vấn đề cấp thiết cần được quan tâm
(TAP) - Trong bối cảnh hiện đại, sức khỏe tâm thần đang trở thành một vấn đề cấp thiết và nóng hổi. Theo các nghiên cứu, tỷ lệ thanh thiếu niên gặp vấn đề về sức khỏe tâm thần đang gia tăng đáng kể gây ảnh hưởng sâu sắc đến nhiều khía cạnh cuộc sống. Do đó, việc nâng cao nhận thức về sức khỏe tâm thần và tạo ra môi trường cải thiện tình hình là cực kỳ cần thiết.

Bệnh dại: Những điều bạn cần biết để phòng tránh
(TAP) - Nhiều người lầm tưởng rằng chỉ có vết cắn từ chó dại mới dẫn đến nguy cơ mắc bệnh, nhưng trên thực tế, virus này còn có thể lây lan qua những vết liếm hay cào từ động vật nhiễm bệnh. Do đó, việc hiểu rõ về bệnh dại là cực kỳ cần thiết để bảo vệ sức khỏe bản thân và gia đình.

Táo tàu: Công dụng và lợi ích sức khỏe
(TAP) - Táo tàu, một loại quả giàu giá trị dinh dưỡng và có nhiều công dụng trong y học cổ truyền, không chỉ mang đến hương vị thơm ngon mà còn chứa đựng nhiều lợi ích cho sức khỏe. Hãy cùng khám phá những tác dụng nổi bật của loại quả đặc biệt này.

5 thói quen xấu gây hại sức khỏe mà bạn không nhận ra
(TAP) - Nhiều người trong chúng ta có những thói quen tưởng chừng như vô hại hoặc không đáng lo ngại, nhưng thực tế, chúng có thể ảnh hưởng xấu đến sức khỏe lâu dài. Đôi khi, chỉ vì chúng ta không nhận ra mối nguy hiểm tiềm ẩn từ những hành động hàng ngày này. Dưới đây là một số thói quen phổ biến có thể gây hại cho sức khỏe mà bạn cần lưu ý, điều chỉnh để bảo vệ cơ thể.

Khám phá lợi ích tuyệt vời của quả ổi cho sức khỏe
(TAP) - Quả ổi là một loại trái cây rất phổ biến trong đời sống hàng ngày của người dân Việt Nam, mang đến không chỉ hương vị thơm ngon mà còn nhiều giá trị dinh dưỡng tuyệt vời. Hãy cùng tìm hiểu về những lợi ích sức khỏe tuyệt vời mà quả ổi mang lại.

Dịch bệnh Legionnaires bùng phát ở New York, 6 người tử vong, 112 ca nhiễm
(TAP) - Đợt bùng phát dịch bệnh Legionnaires tại khu vực Central Harlem, Thành phố New York (bang New York) tiếp tục diễn biến phức tạp. Theo thông tin từ Sở Y tế địa phương, tính đến ngày 22/8, ghi nhận có 6 người tử vong, 112 ca nhiễm bệnh và 7 trường hợp đang điều trị.

Texas tuyên bố dịch sởi chính thức kết thúc ở địa phương
(TAP) - Mới đây, Sở Dịch vụ Y tế Tiểu bang Texas tuyên bố dịch sởi từng gây lo ngại trên diện rộng chính thức kết thúc ở địa phương này. Tiểu bang không ghi nhận thêm bất kỳ ca bệnh mới nào suốt hơn 42 ngày qua tại những khu vực có dấu hiệu lây lan.

Khuyến cáo về vaccine COVID-19 cho trẻ: AAP và CDC bất đồng quan điểm
(TAP) - Viện Hàn lâm Nhi khoa Hoa Kỳ (AAP) vừa đưa ra hướng dẫn tiêm chủng mới về vaccine COVID-19 cho trẻ em. Tuy nhiên, theo công bố, ghi nhận lần đầu tiên trong 30 năm qua, AAP bất đồng quan điểm trước khuyến cáo từ Chính phủ liên bang, cụ thể là Trung tâm Kiểm soát và Phòng ngừa Dịch bệnh Hoa Kỳ (CDC).

Bắt kịp xu thế, FDA ra mắt công cụ AI để tối ưu hiệu suất phục vụ
(TAP) - Với mục tiêu tối ưu hiệu suất phục vụ trong mọi hoạt động, Cục Quản lý Thực phẩm và Dược phẩm Hoa Kỳ (FDA) vừa ra mắt trí tuệ nhân tạo (AI) tạo sinh mang tên “Elsa”. Đây là công cụ được đánh giá có thể giúp người dân rút ngắn thời gian xin cấp phép thuốc, xử lý nhanh thông tin trên các tờ hướng dẫn sử dụng.

Bộ Y tế Việt Nam cảnh báo Sốt Xuất Huyết, COVID-19 tăng năm 2025
(TAP) - Mới đây, Bộ Y tế Việt Nam cảnh báo khẩn về sự gia tăng sốt xuất huyết, COVID-19 trong năm 2025. Người dân cần đeo khẩu trang, rửa tay thường xuyên để phòng dịch hiệu quả.

Số ca nhiễm COVID-19 tại Thái Lan tăng nhanh vì biến thể XEC
(TAP) - Mới đây, ngành y tế Thái Lan nâng cao mức cảnh báo trước sự bùng phát nhanh chóng của biến thể của COVID-19 mang tên XEC - một hậu duệ của biến thể Omicron.

FDA siết chặt tiêu chuẩn phê duyệt vaccine COVID-19 cho người khỏe mạnh
(TAP) - Cục Quản lý Thực phẩm và Dược phẩm Hoa Kỳ (FDA) vừa điều chỉnh quy trình phê duyệt các mũi tiêm tăng cường vaccine COVID-19, với các tiêu chuẩn nghiêm ngặt hơn đối với người khỏe mạnh. Động thái này đánh dấu sự thay đổi đáng kể trong cách tiếp cận chính sách tiêm chủng của Hoa Kỳ, đồng thời có thể ảnh hưởng đến khả năng tiếp cận vaccine hàng năm của hàng triệu người.

Cục Quản lý Thực phẩm và Dược phẩm Hoa kỳ phê duyệt xét nghiệm HPV tại nhà
(TAP) - Ngày 9/5, Cục Quản lý Thực phẩm và Dược phẩm Hoa Kỳ (FDA) đã chính thức phê duyệt xét nghiệm HPV tại nhà. Động thái đánh dấu bước tiến quan trọng trong việc cải thiện khả năng tiếp cận tầm soát ung thư cổ tử cung cho phụ nữ.

Việt Nam công bố 21 loại thuốc bị làm giả
(TAP) - Liên quan đến vụ án sản xuất, buôn bán thuốc tân dược giả với quy mô lớn lan rộng trên khắp lãnh thổ Việt Nam do Công an tỉnh Thanh Hóa triệt phá, Cục Quản lý Dược (Bộ Y tế Việt Nam) đã có Công văn số 113/QLD-CL công bố danh sách đầy đủ 21 loại thuốc bị làm giả. Vụ việc một lần nữa gióng lên hồi chuông cảnh báo về sự tinh vi ngày càng cao của các loại thuốc giả đang âm thầm len lỏi vào thị trường, đe dọa nghiêm trọng đến sức khỏe cộng đồng.

Táo tàu: Công dụng và lợi ích sức khỏe
(TAP) - Táo tàu, một loại quả giàu giá trị dinh dưỡng và có nhiều công dụng trong y học cổ truyền, không chỉ mang đến hương vị thơm ngon mà còn chứa đựng nhiều lợi ích cho sức khỏe. Hãy cùng khám phá những tác dụng nổi bật của loại quả đặc biệt này.

5 thói quen xấu gây hại sức khỏe mà bạn không nhận ra
(TAP) - Nhiều người trong chúng ta có những thói quen tưởng chừng như vô hại hoặc không đáng lo ngại, nhưng thực tế, chúng có thể ảnh hưởng xấu đến sức khỏe lâu dài. Đôi khi, chỉ vì chúng ta không nhận ra mối nguy hiểm tiềm ẩn từ những hành động hàng ngày này. Dưới đây là một số thói quen phổ biến có thể gây hại cho sức khỏe mà bạn cần lưu ý, điều chỉnh để bảo vệ cơ thể.

Cảnh báo nguy cơ ngộ độc botulinum từ thực phẩm
(TAP) - Ngộ độc botulinum (còn gọi là ngộ độc thịt) là một trong những dạng ngộ độc nguy hiểm nhất, có thể gây tử vong nếu không được phát hiện và điều trị kịp thời.

Bùng phát bệnh sởi tại châu Âu: WHO, UNICEF phát cảnh báo
(TAP) - Tại cuộc họp ở Geneva, Thụy Sĩ vào ngày 14/3/2025, Tổ chức Y tế Thế giới (WHO) và Quỹ Nhi đồng Liên Hợp Quốc (UNICEF) báo động về sự gia tăng đáng lo ngại của bệnh sởi tại khu vực châu Âu.

Dịch sởi bùng phát mạnh, Bộ Y tế Việt Nam họp khẩn
(TAP) - Trước tình hình bệnh sởi diễn biến phức tạp với số ca mắc tiếp tục ở mức cao và nguy cơ gia tăng vào thời gian tới, Bộ Y tế Việt Nam tổ chức cuộc họp khẩn vào ngày 15/3 tại Hà Nội nhằm đề ra các biện pháp phòng, chống hiệu quả.

Việt Nam: Vaccine Rota sẽ được triển khai miễn phí trên toàn quốc
(TAP) - Theo thông tin từ Cổng thông tin Chính phủ Việt Nam, Vaccine Rota phòng tiêu chảy cấp sẽ được triển khai miễn phí tại các cơ sở y tế trên toàn Việt Nam trong Chương trình Tiêm chủng mở rộng. Như vậy, cha mẹ, người chăm sóc trẻ có thể đưa trẻ đến các trạm y tế để được uống vaccine.

Cảnh báo nguy cơ dịch bệnh gia tăng trong mùa nồm ẩm
(TAP) - Mùa xuân miền Bắc với đặc trưng nồm ẩm, mưa phùn kéo dài kết hợp cùng các hoạt động lễ hội đầu năm thu hút đông người tạo điều kiện thuận lợi cho sự phát triển của nhiều loại virus gây bệnh đường hô hấp. Những nhóm đối tượng như người cao tuổi, trẻ em, người mắc bệnh nền, người có hệ miễn dịch suy giảm cần cẩn trọng trước nguy cơ nhiễm cúm và các bệnh truyền nhiễm khác.

Những trường hợp nào không nên uống rượu để tránh tổn thương gan?
(TAP) - Các nhà khoa học cảnh báo, người có vòng bụng to, mặc bệnh tiểu đường hoặc huyết áp cao có nguy cơ tăng gấp đôi tổn thương gan khi uống rượu. Không chỉ gây hại gan, nhiều nghiên cứu còn cho thấy, rượu là nguyên nhân gây ra gần 100.000 trường hợp ung thư ở Hoa Kỳ.

Cảnh báo lạm dụng Tamiflu trong điều trị cúm mùa
(TAP) - Mùa đông xuân là thời điểm bệnh cúm mùa gia tăng mạnh mẽ, đặc biệt là sau Tết Nguyên Đán, khi nhu cầu giao thương, du lịch và tụ tập đông người tăng cao. Trong bối cảnh này, một vấn đề đáng lo ngại đã nảy sinh: nhiều người dân tự ý mua thuốc Tamiflu để điều trị cúm tại nhà mà không có sự hướng dẫn của bác sĩ. Các chuyên gia y tế cảnh báo về nguy cơ lạm dụng thuốc và những hậu quả nghiêm trọng đối với sức khỏe cộng đồng.

Cúm mùa: Hiểm họa tiềm ẩn cần đặc biệt chú ý
(TAP) - Cúm mùa là một bệnh nhiễm trùng đường hô hấp cấp tính do virus cúm (Influenza virus) thuộc họ Orthomyxoviridae gây ra. Theo Tổ chức Y tế Thế giới (WHO), cúm mùa lưu hành trên toàn cầu, lây lan nhanh qua đường hô hấp, giọt bắn khi nói chuyện, hắt hơi hoặc qua tiếp xúc với bề mặt có virus. Đáng chú ý, virus có thể lây từ người bệnh ngay cả trước khi triệu chứng xuất hiện một ngày.

Khám phá lợi ích tuyệt vời của quả ổi cho sức khỏe
(TAP) - Quả ổi là một loại trái cây rất phổ biến trong đời sống hàng ngày của người dân Việt Nam, mang đến không chỉ hương vị thơm ngon mà còn nhiều giá trị dinh dưỡng tuyệt vời. Hãy cùng tìm hiểu về những lợi ích sức khỏe tuyệt vời mà quả ổi mang lại.

Việt Nam: Bộ Y tế muốn phạt nặng người dùng thuốc lá điện tử
(TAP) - Trước thực trạng thuốc lá điện tử và thuốc lá nung nóng lan rộng trong giới trẻ, đe dọa sức khỏe cộng đồng, Bộ Y tế Việt Nam đề xuất phạt tiền người sử dụng lên đến 2.000.000 đồng.

Bụi mịn – hiểm hoạn vô hình tàn phá sức khỏe con người
(TAP) - Trong suốt những năm qua, ô nhiễm không khí đã trở thành một vấn đề toàn cầu cấp bách, không phải do sự ầm ĩ hay sự hiện diện rõ rệt của nó, mà bởi những kẻ vô hình đang dần tàn phá sức khỏe hàng tỷ người - bụi mịn. Liệu chúng ta có đủ nhận thức để đối mặt với mối đe dọa âm thầm nhưng vô cùng nguy hiểm này?

Việt Nam cảnh giác trước dịch bệnh viêm phổi HMPV từ Trung Quốc
(TAP) - Chiều ngày 05/1, Bộ Y tế Việt Nam chính thức cung cấp thông tin về dịch bệnh viêm phổi do virus human metapneumovirus (HMPV) đang được đề cập tại Trung Quốc.

Nguyên nhân nào khiến người trung niên dễ tăng cân?
(TAP) - Tuổi trung niên là một giai đoạn quan trọng trong cuộc đời, nơi con người tích lũy nhiều kinh nghiệm, thành tựu đồng thời đối mặt với những thay đổi lớn lao. Bên cạnh những niềm vui, thử thách, không ít người phải đối diện với một vấn đề thường xuyên gây phiền toái: tăng cân. Hiện tượng này không chỉ ảnh hưởng đến ngoại hình mà còn tiềm ẩn nhiều nguy cơ sức khỏe đáng lo ngại. Vậy nguyên nhân nào khiến người trung niên dễ tăng cân và làm thế nào để kiểm soát hiệu quả vấn đề này?

Dự báo năm 2025, dịch bệnh vẫn phát triển phức tạp
(TAP) - Vào năm 2025, tình hình dịch bệnh toàn cầu tiếp tục phát triển phức tạp, với những nguy cơ từ các bệnh truyền nhiễm mới, đặc biệt là các bệnh lây từ động vật sang người, tiềm ẩn nhiều rủi ro.

Ngộ độc rượu – Nguy cơ đe dọa sức khỏe và tính mạng
(TAP) - Theo thông tin từ Cục An toàn thực phẩm - Bộ Y tế Việt Nam, trong thời gian gần đây, số lượng trường hợp ngộ độc rượu gia tăng đáng kể, dẫn đến nhiều ca phải nhập viện cấp cứu và thậm chí tử vong. Đây là vấn đề nghiêm trọng cần được cộng đồng quan tâm và có biện pháp ngăn chặn kịp thời.

Ô nhiễm không khí: nguy cơ tiềm ẩn với sức khỏe tâm thần
(TAP) - Các nhà nghiên cứu từ Đại học St Andrews (Vương quốc Anh) vừa công bố một nghiên cứu quy mô lớn, tiết lộ mối liên hệ đáng lo ngại giữa ô nhiễm không khí và tỷ lệ nhập viện vì các bệnh tâm thần. Đây là nghiên cứu được đánh giá toàn diện nhất trong lĩnh vực này tính đến thời điểm hiện tại.

Nga chuẩn bị công bố vaccine điều trị ung thư vào năm 2025
(TAP) - Vào ngày 15/12 (giờ địa phương), giới truyền thông Nga đồng loạt đưa tin về bước tiến quan trọng trong lĩnh vực y học tại nước này. Theo đó, Bộ Y tế Nga dự kiến công bố vaccine điều trị ung thư EnteroMix và tiến hành thử nghiệm lâm sàng vào đầu năm 2025, mở ra một hướng đi mới trong việc chữa trị cho những bệnh nhân.

Nguy cơ dịch bệnh Congo: Cộng đồng quốc tế đẩy mạnh phòng chống
(TAP) - Trước tình hình dịch bệnh bí ẩn bùng phát tại Congo, nhiều quốc gia tăng cường kiểm soát tại sân bây và phát đi cảnh báo khuyến cáo người dân.

Việt Nam cấm thuốc lá điện tử, các loại khí, chất gây nghiện từ năm 2025
(TAP) - Quốc hội Việt Nam vừa thống nhất thông qua luật cấm sử dụng thuốc lá điện tử, các loại khí, chất gây nghiện áp dụng từ năm 2025. Bên cạnh đó, việc sản xuất, kinh doanh, nhập khẩu, chứa chấp, vận chuyển nhóm mặt hàng này cũng bị liệt vào hành vi vi phạm pháp luật.

Kiến ba khoang có độc tố mạnh gấp 12 – 15 lần nọc rắn hổ
(TAP) - Kiến ba khoang, còn được gọi là kiến khoang, kiến kim hay kiến lác, là một loài côn trùng có chứa độc tố cực kỳ mạnh. Độc tố Pederin trong loài kiến này mạnh gấp 12-15 lần so với nọc rắn hổ. Tuy nhiên, vì độc tố này chỉ xâm nhập vào cơ thể qua da, với lượng nhỏ nên không đủ gây tử vong nhưng đủ sức gây bỏng rát, viêm nhiễm nếu tiếp xúc với da. Vì vậy, việc phòng tránh tiếp xúc với loài kiến này là rất cần thiết để bảo vệ sức khỏe.

Nguy cơ sức khỏe tâm lý từ mạng xã hội: Cảnh giác kẻo muộn!
(TAP) - Trong xã hội hiện đại, sự phát triển mạnh mẽ của công nghệ thông tin và mạng xã hội đã tác động sâu rộng đến mọi mặt trong đời sống con người. Dễ dàng nhận thấy, công nghệ mang lại nhiều tiện ích, giúp con người kết nối nhanh chóng, chia sẻ thông tin và nâng cao hiệu quả công việc. Tuy nhiên, bên cạnh những mặt tích cực, không thể phủ nhận rằng công nghệ, đặc biệt là mạng xã hội, cũng đang dần trở thành một tác nhân gây hại cho sức khỏe tâm lý của con người. Những tác động tiêu cực này ngày càng trở nên rõ rệt và đáng lo ngại.

Thuốc lá điện tử không phải phương pháp cai thuốc lá hiệu quả
(TAP) - Thuốc lá điện tử, thuốc lá nung nóng không phải phương pháp hỗ trợ cai thuốc lá hiệu quả. Thực tế, thanh thiếu niên sử dụng thuốc lá điện tử có khả năng bắt đầu hút thuốc lá thông thường cao gấp ba lần so với những người không sử dụng.

Bệnh dại: Những điều bạn cần biết để phòng tránh
(TAP) - Nhiều người lầm tưởng rằng chỉ có vết cắn từ chó dại mới dẫn đến nguy cơ mắc bệnh, nhưng trên thực tế, virus này còn có thể lây lan qua những vết liếm hay cào từ động vật nhiễm bệnh. Do đó, việc hiểu rõ về bệnh dại là cực kỳ cần thiết để bảo vệ sức khỏe bản thân và gia đình.

Bộ Y tế Việt Nam chỉ đạo khẩn trước dịch bệnh Marburg
(TAP) - Cục Y tế dự phòng - Bộ Y tế Việt Nam vừa phát đi văn bản chỉ đạo triển khai các biện pháp, tăng cường giám sát người nhập nhập cảnh nhằm kiểm soát dịch bệnh Marburg. Đây là một căn bệnh có khả năng lây truyền và tỷ lệ tử vong cao lên đến 88%.

Bí quyết duy trì sự minh mẫn của những người sống thọ
(TAP) - Cuộc sống trường thọ không chỉ là sống lâu, mà còn phải sống khỏe mạnh và tràn đầy năng lượng. Người sống thọ nhưng vẫn duy trì sự minh mẫn thường có lối sinh hoạt và thói quen rất cụ thể. Hãy khám phá bí quyết của những người sống thọ để cùng tận hưởng hành trình này.

Các lợi ích sức khỏe từ quả bơ
(TAP) - Bơ là một trái cây phổ biến có giá trị dinh dưỡng cao gồm hơn 20 loại vitamin, chất xơ, chất béo và khoáng chất kali, lutein, folate. Chính vì thế, loại quả này được xem như một siêu thực phẩm mang lại nhiều lợi ích sức khỏe.

5 lý do cho thấy giấc ngủ rất quan trọng
(TAP) - Ngoài việc ăn uống lành mạnh và tập thể dục thường xuyên, ngủ đủ giấc cũng là một trong các yếu tố quan trọng mà mọi người cần chú ý để duy trì sức khỏe bền vững. Vậy tại sao một giấc ngủ ngon và chất lượng lại quan trọng đến thế?

Một số bệnh có nguy cơ bùng phát trong mùa mưa bão
(TAP) - Cơn bão số 3 (Yagi) đi qua đã gây không ít thiệt hại về tính mạng và tài sản của người dân. Không dừng lại ở đó, sau mùa mưa bão, nguy cơ bùng phát dịch bênh khá cao khi môi trường trở nên ô nhiễm, ẩm thấp, tích tụ vi khuẩn, bụi rác, chất thải, …Chính vì thế người dân nên chú ý đề phòng một số bệnh có thể xảy trong mùa mưa bão để hạn chế tối đa bị lây nhiễm.

Doanh nghiệp Nhật Bản phải báo cáo ảnh hưởng từ thực phẩm chức năng
(TAP) - Bắt đầu từ ngày 01/09, các doanh nghiệp Nhật Bản phải báo cáo cụ thể những ảnh hưởng sức khỏe từ chất bổ sung, sản phẩm dán nhãn “có lợi cho sức khỏe” và “thực phẩm bổ sung” cho cơ quan chức năng.

Việt Nam: Tăng cường các biện pháp phòng, chống và kiểm soát dịch bệnh sởi
(TAP) - Tình hình dịch bệnh sởi có nguy cơ bùng phát tại Việt Nam, để đảm bảo vắc xin sởi luôn sẵn có, Bộ Y tế Việt Nam đã chủ động phối hợp với các đơn vị liên quan để sử dụng ngân sách trung ương mua sắm vắc xin và nhận viện trợ từ Chính phủ Úc.

Một số công dụng tốt cho sức khỏe của ớt chuông
(TAP) - Ớt chuông (bell peper) là một loại quả mọng dày thịt, nhiều hạt, có nguồn gốc từ vùng Trung, Nam Mĩ. Loại quả này có thể ăn sống hoặc nấu cùng với các loại thực phẩm khác để tăng thêm màu sắc và hương vị cho các món ăn. Nhờ chứa hàm lượng dinh dưỡng cao, việc bổ sung ớt chuông vào bữa ăn có thể mang lại nhiều công dụng tốt cho sức khỏe.

Bộ Y tế Việt Nam triển khai thêm 4 vaccine miễn phí
(TAP) - Bộ Y tế Việt Nam sẽ triển khai thêm 4 vaccine miễn phí vào chương trình “Tiêm chủng mở rộng”, nhằm tăng cơ hội phòng bệnh cho người dân. Trong đó bao gồm vaccine ngăn ngừa ung thư cổ tử cung, vaccine phòng cúm mùa, vaccine phòng bệnh do virus Rota và vaccine phòng bệnh do phế cầu.

Phụ nữ mang thai được khuyến cáo tiêm vắc xin phòng bệnh ho gà
(TAP) - Bộ Y tế Việt Nam khuyến cáo phụ nữ mang thai trong kỳ thứ 3 (khoảng tuần thai từ 27 đến 36) tiêm vắc xin phòng ho gà giúp bảo vệ người mẹ khỏi nhiễm bệnh, cung cấp khả năng miễn dịch thụ động cho trẻ sơ sinh.

Dấu hiệu và triệu chứng của bệnh đậu mùa khỉ
(TAP) - Đậu mùa khỉ là một bệnh truyền nhiễm vô cùng nguy hiểm đối với sức khỏe con người. Đặc biệt là khi thời gian vừa qua, vào ngày 14/08, Tổ chức Y tế Thế giới (WHO) đưa ra cảnh báo tình trạng khẩn cấp toàn cầu với bệnh nhiễm trùng từ virus đậu mùa khỉ. Thế nên, việc tìm hiểu nhận biết sớm các dấu hiệu và triệu chứng của bệnh đậu mùa khỉ là vô cùng cần thiết để phòng ngừa và điều trị kịp thời.

Cần tăng cường bảo vệ trẻ em trước bệnh sởi
Ngày 15/08, Bộ Y tế Việt Nam khuyến cáo các phụ huynh tăng cường biện pháp bảo vệ trẻ em trước bệnh sởi - một bệnh truyền nhiễm vô cùng nguy hiểm.

WHO: Cảnh báo tình trạng khẩn cấp toàn cầu với bệnh nhiễm trùng do virus đậu mùa khỉ
(TAP) - Mới đây, Tổng giám đốc Tổ chức Y tế Thế giới đã tuyên bố đợt bùng phát bệnh mpox (bệnh nhiễm trùng gây ra do virus đậu mùa khỉ) ở Châu Phi là tình trạng khẩn cấp về sức khỏe toàn cầu.

Hoa Kỳ: Thu hồi hàng loại sản phẩm kem đóng hộp vì nguy cơ gây ngộ độc, tử vong
(TAP) - Nếu đang sở hữu một trong những sản phẩm kem đóng hộp này trong nhà (danh sách bên dưới), công dân nên lập tức tiêu hủy, gửi sản phẩm về nơi sản xuất hoặc điểm bán để được hoàn tiền. Nếu bất chấp sử dụng các sản phẩm bị khuyến cáo, người dùng sẽ có nguy cơ gây ngộ độc hoặc thậm chí tử vong

Nevada: Muỗi mang virus West Nile tăng đáng kể ở thung lũng Las Vegas, địa phương lên tiếng cảnh báo
(TAP) - Các quan chức y tế Las Vegas (bang Nevada) cho biết, quá trình lây lan của Virus “West Nile” qua muỗi vằn tăng mạnh suốt thời gian qua. Trong bối cảnh nhiều trường hợp nhiễm bệnh có thể chuyển nặng, thậm chí tử vong, địa phương đã lên tiếng cảnh báo, hướng dẫn công dân một số biện pháp phòng ngừa, giữ an toàn cho bản thân và gia đình.

Vì sao trước khi ngủ nên đọc sách?
(TAP) - Giữa nhịp sống hối hả và bận rộn, nhiều người tìm đến giấc ngủ như một liều thuốc cho tinh thần và thể chất. Tuy nhiên, để có một giấc ngủ ngon và trọn vẹn, không chỉ đơn giản là chìm vào giấc ngủ mà còn cần sự chuẩn bị kỹ lưỡng. Và một trong những bí quyết đơn giản nhưng hiệu quả chính là thói quen đọc sách trước khi ngủ.

Những công dụng bất ngờ từ nước chanh mật ong
(TAP) - Theo nhiều nghiên cứu, chanh và mật ong kết hợp có thể mang lại nhiều lợi ích cho sức khỏe. Khi bạn uống nước chanh mật ong hàng ngày sẽ thấy được những thay đổi bất ngờ.

Hoa Kỳ: Thêm sản phẩm bị thu hồi vì nghi chứa vi khuẩn E. coli
(TAP) - Dịch vụ Kiểm tra An toàn Thực phẩm (Food Safety and Inspection Service, viết tắt: FSIS) thuộc Bộ Nông nghiệp (Department of Agriculture) cho biết, lượng lớn thịt bò xay tươi (sống) vừa bị thu hồi vì nghi nhiễm nhiễm E. coli O157:H7 (gọi tắt E. coli). Đáng nói rằng đây không phải lần duy nhất trong vòng 7 ngày qua có sản phẩm bị thu hồi liên quan đến vi khuẩn gây bệnh truyền nhiễm.

California - Washington: Thu hồi sản phẩm có chứa vi khuẩn E. coli gây tử vong
(TAP) - Trang trại Gibson (Gibson Farms) vừa thông báo thu hồi quả óc chó (dạng miếng hoặc nửa miếng) được bán cho các nhà phân phối ở bang California và Washington. Tuyên bố trên xuất hiện sau khi có thông tin cho rằng sản phẩm từ nông trại này chứa vi khuẩn E. Coli 0157:H7. E. coli O157:H7 (viết tắt E. coli) gây bệnh truyền nhiễm.

Hoa Kỳ: Đảm bảo quyền lợi cho nhân viên chăm sóc y tế tại nhà
(TAP) - Phó Tổng Thống Hoa Kỳ Kamala Harris vừa thông tin về những kết quả đạt được trong việc cải thiện khả năng tiếp cận dịch vụ và hỗ trợ người dân cần chăm sóc. Đồng thời, bà Harris cũng công bố một quy tắc mới vừa hoàn thiện, giúp cải thiện khả năng tiếp cận các dịch vụ chăm sóc tại nhà cũng như cải thiện chất lượng công việc chăm sóc về chăm sóc tại gia.

California (Hoa Kỳ): Xuất hiện muỗi vằn gây bệnh ở Quận Santa Clara
(TAP) - Aedes aegypti - loài muỗi vằn gây bệnh truyền nhiễm sốt xuất huyết và sốt da vàng, vừa được phát hiện tại khu dân cư ở Đông San José (Quận Santa Clara, bang California). Trước nguy cơ bùng phát đợt xấm lấn, chính quyền địa phương đã kêu gọi cộng đồng chú ý và chung tay tiêu diệt loài gây hại.

Hoa Kỳ: Thu hồi hàng triệu túi bột giặt gây nguy hại sức khỏe
(TAP) - Gần 8,2 triệu túi bặt giặt thương hiệu Tide, Gain, Ace và Ariel phân phối ở thị trường Hoa Kỳ vừa bị Ủy ban An toàn Sản phẩm Tiêu dùng (Consumer Product Safety Commission, viết tắt: CPSC) và Procter & Gamble (P&G) - tập đoàn tiêu dùng đa quốc gia có trụ sở tại Ohio đưa ra tuyên bố thu hồi.

California (Hoa Kỳ): Cảnh báo nguy cơ nhiễm chì từ sản phẩm kem trị trĩ
(TAP) - Sau vụ người phụ nữ ở Sacramento tử vong do nhiễm chì vì bôi thuốc trị trĩ không rõ nguồn gốc có tên “Cao Boi Tri Cay Thau Dau”, Sở Y tế Công cộng California (California Department of Public Health, viết tắt: CDPH) đã ban hành lệnh thu hồi sản phẩm.

Hoa Kỳ: Mở rộng khả năng tiếp cận y tế trên toàn thế giới
Kể từ sau thảm họa COVID-19, cùng với việc đẩy mạnh đầu tư nhằm chuẩn bị tốt hơn cho những đại dịch tiếp theo, Hoa Kỳ đang hỗ trợ các nước trên thế giới mở rộng khả năng tiếp cận biện pháp ứng phó trong lĩnh vực y tế.

Tác hại của việc thức khuya thường xuyên
Theo nhịp sống hiện đại đầy bận rộn, nhiều người thường duy trì thói quen thức khuya dù biết đây là một thói quen không tốt cho sức khỏe. Thức khuya thường xuyên không chỉ khiến cơ thể mệt mỏi, cạn kiệt năng lượng, suy giảm sức đề kháng mà còn tiềm ẩn những tác hại khôn lường đối với sức khỏe.

CDC Hoa Kỳ khuyến khích tiêm chủng nirsevimab ngăn ngừa RSV cho trẻ
Nghiên cứu mới đây của các chuyên gia y tế cho thấy, kháng thể nirsevimab có tác dụng kéo dài và bảo vệ trẻ sơ sinh khỏi nhập viện do virus hợp bào hô hấp (Respiratory Syncytial Virus Infection, viết tắt: RSV).

Những lợi ích tuyệt vời của cà phê đối với sức khỏe
Cà phê là loại thức uống quen thuộc được nhiều người ưu chuộng, với nhiều loại khác nhau cùng cách pha chế cũng vô cùng đa dạng, hấp dẫn. Ngoài việc giúp tinh thần trở nên tỉnh táo hơn, cà phê còn đem đến những lợi ích tuyệt vời cho sức khỏe.

Hoa Kỳ: Tìm thấy chất gây ung thư trong sản phẩm trị mụn
Cục quản lý Thực phẩm và Dược phẩm (Food and Drug Administration, viết tắt: FDA) Hoa Kỳ vừa nhận được đơn đề nghị thu hồi một số sản phẩm trị mụn thương hiệu Clearasil, Proactiv, Clinique,… Nguyên nhân vì chúng chứa nhiều benzoyl peroxide - hàm lượng hóa chất có nguy cơ gây ung thư.

FDA cảnh báo loạt siêu thị vẫn bán sữa gây ngộ độc botulinum
(TAP) - Vừa qua, Cục Quản lý Thực phẩm và Dược phẩm Hoa Kỳ (FDA) gửi thư cảnh báo hàng loạt chuỗi bán lẻ tại Hoa Kỳ vẫn bày bán sữa công thức cho trẻ sơ sinh ByHeart Whole Nutrition - sản phẩm đã bị thu hồi trên toàn quốc vì gây nhiều ca ngộ độc Botulinum.

WHO khẳng định vắc xin không gây ra chứng tự kỷ
(TAP) - Tổ chức Y tế thế giới (WHO) vừa tái khẳng định lập trường vắc xin không gây ra chứng tự kỷ. Đây là kết quả nghiên cứu mới nhất do Ủy ban Tư vấn toàn cầu về an toàn vắc xin (GACVS) công bố dựa trên bằng chứng hiện có.

Công nghệ in 3D FITme - “Làn sóng” mới trong Phẫu thuật Thẩm mỹ hiện nay
(TAP) - Sự trỗi dậy của công nghệ mô phỏng và máy móc tự động hóa đang tạo ra một cuộc cách mạng trong mọi lĩnh vực đời sống, từ y tế, sản xuất đến dịch vụ. Trong đó, lĩnh vực phẫu thuật thẩm mỹ đã chứng kiến những bước tiến đáng kể nhất. Việc ứng dụng công nghệ in 3D không chỉ dừng lại ở việc hỗ trợ chẩn đoán mà đã tham gia sâu vào quá trình thiết kế vật liệu cấy ghép, mang đến độ chính xác và tính cá nhân hóa vượt trội.

Việt Nam nỗ lực chấm dứt HIV/AIDS
(TAP) - Việt Nam đang đẩy mạnh các giải pháp phòng, chống HIV/AIDS trong bối cảnh số ca nhiễm mới còn cao và nhiều thách thức kéo dài. Mở rộng các biện pháp dự phòng, bảo đảm điều trị không gián đoạn, giảm kỳ thị với người nhiễm được coi là những yếu tố quyết định để Việt Nam tiến gần mục tiêu chấm dứt HIV/AIDS vào năm 2030.

WHO: Số ca mắc sởi toàn cầu tăng trở lại
(TAP) - Tổ chức Y tế Thế giới (WHO) cho biết số ca mắc sởi đang tăng lên trên toàn cầu, trong khi số ca tử vong do bệnh này tiếp tục giảm. Đặc biệt ở Hoa Kỳ, giữa bối cảnh tỷ lệ tiêm chủng trẻ em giảm và tâm lý hoài nghi vaccine gia tăng, giới chức y tế nước này gần đây ghi nhận số ca mắc sởi đạt mức cao nhất kể từ năm 2000.

WHO tuyên bố chấm dứt đợt bùng phát virus gây bại liệt ở Indonesia
(TAP) - Tổ chức Y tế Thế giới (WHO) thông báo, đợt bùng phát virus gây bại liệt tại Indonesia chính thức kết thúc sau gần 3 năm nỗ lực kiểm soát. Thông tin xuất hiện sau khi WHO xác nhận không còn virus lây lan ở trẻ em hoặc trong môi trường sống kể từ tháng 6/2024.

Việt Nam: Trẻ em được tiêm miễn phí vaccine Rota từ 2026
(TAP) - Tại Việt Nam, từ năm 2026, trẻ em sẽ được uống miễn phí vaccine Rota, tiêm HPV và tiếp tục tiếp cận vaccine phế cầu theo lộ trình mở rộng. Đây là bước tiến trong kế hoạch đưa các vaccine mới vào Chương trình tiêm chủng mở rộng giai đoạn 2021-2030.

Việt Nam: Thu hồi loạt kem chống nắng giả
(TAP) - Cục Quản lý Dược (Bộ Y tế Việt Nam), vừa đình chỉ lưu hành, thu hồi kem chống nắng LYZEEN SPF50+ PA++++ và Gel Panda Baby Bạch Liên. Kết quả kiểm nghiệm kem chống nắng LYZEEN là “hàng giả” có chỉ số SPF thấp hơn 70% so với công bố, trong khi Gel Panda Baby không đạt giới hạn vi sinh vật, tiềm ẩn nguy cơ cho người tiêu dùng.

Bộ Y tế yêu cầu điều tra vụ ngộ độc bánh mì tại TP. HCM
(TAP) - Liên quan đến vụ hàng trăm người bị ngộ độc thực phẩm do ăn bánh mì, Bộ Y tế Việt Nam vừa yêu cầu tổ chức điều tra, truy xuất nguồn gốc thực phẩm và xử lý nghiêm vi phạm (nếu có).

Tỏi - Thần dược phòng ngừa ung thư
(TAP) - Tỏi từ lâu đã được biết đến không chỉ là một loại gia vị phổ biến khi nấu ăn mà còn là một “thần dược” ở lĩnh vực y học. Ngày nay, nhiều nghiên cứu hiện đại đã chỉ ra rằng tỏi có tiềm năng lớn phòng ngừa ung thư, nhờ vào những hợp chất đặc biệt có trong loại củ này.

FDA hạn chế bán sản phẩm chứa fluoride chưa phê duyệt cho trẻ
(TAP) - Cục Quản lý Thực phẩm và Dược phẩm Hoa Kỳ (FDA) mới đây đã công bố các biện pháp nhằm hạn chế việc bán, sử dụng sản phẩm chứa fluoride chưa được phê duyệt cho trẻ em. Bộ trưởng Bộ Y tế và Dịch vụ Nhân sinh (HHS) Robert F. Kennedy Jr tuyên bố, quyết định trên thể hiện nỗ lực từ Chính phủ trong việc bảo vệ sức khỏe nhóm dễ bị tổn thương, cần ưu tiên bảo vệ.

Hoa Kỳ: Tỷ lệ béo phì giảm nhưng tỷ lệ tiểu đường cao kỷ lục
(TAP) - Tỷ lệ béo phì tại Hoa Kỳ đang có dấu hiệu giảm suốt 3 năm qua - trùng với thời điểm ngày càng nhiều người sử dụng thuốc giảm cân chứa hoạt chất GLP-1. Mặc dù vậy, số người mắc bệnh tiểu đường, dựa trên chẩn đoán từ bác sĩ năm 2024, vẫn đạt mức cao kỷ lục.

FDA Thái Lan cảnh báo dầu hít Hong Thai nhiễm vi sinh
(TAP) - Mới đây, Cục Quản lý Thực phẩm và Dược phẩm Thái Lan (FDA) đã công bố kết quả kiểm tra dầu hít mũi Hong Thai, phát hiện sản phẩm vi phạm tiêu chuẩn kỹ thuật và nhiễm khuẩn vượt mức quy định. Do đó, cơ quan phát cảnh báo để người tiêu dùng ngưng sử dụng.

Lá húng chanh - Thảo dược dân gian trị ho, giải cảm, tăng cường sức khỏe
(TAP) - Lá húng chanh, còn gọi là tần dày lá hay dương tử tô, là thảo dược dân gian quen thuộc, thường xuất hiện trong bữa cơm gia đình như rau gia vị và được xem là vị thuốc quý. Nhờ chứa nhiều hoạt chất có lợi, húng chanh giúp cơ thể kháng khuẩn, giảm viêm, tiêu đờm, trị ho, giải cảm và tăng cường sức đề kháng tự nhiên.

Thuốc tiêm ngừa HIV sắp được triển khai ở nhiều quốc gia
(TAP) - Lenacapavir là một loại thuốc ngăn ngừa lây nhiễm HIV tiên tiến nhất hiện nay, đạt hiệu quả gần 100% qua nhiều thử nghiệm. Nó sắp được triển khai tại Zimbabwe và nhiều quốc gia châu Phi.

Cây chùm bao: Vị thuốc quý từ thiên nhiên
(TAP) - Trong kho tàng dược liệu Việt Nam, cây chùm bao (hay cây lạc tiên, dây nhãn lồng) từ lâu được sử dụng như loài thảo mộc dân dã ẩn chứa nhiều giá trị y học quý báu. Loại cây này không chỉ là bài thuốc giúp con người tìm lại giấc ngủ an yên mà còn hỗ trợ tinh thần thư thái giữa nhịp sống hiện đại.

WHO: Bệnh lý thần kinh gây hơn 11 triệu ca tử vong mỗi năm
(TAP) - Tổ chức Y tế Thế giới (WHO) mới đây phát đi cảnh báo các quốc gia cần tăng cường đầu tư và chăm sóc bệnh lý liên quan đến thần kinh. WHO nhấn mạnh đây là nhóm bệnh gây ra hơn 11 triệu ca tử vong mỗi năm, ảnh hưởng đến hơn 3 tỷ người, tương đương 40% dân số toàn cầu.

WHO cảnh báo sự lây lan nhanh chóng của siêu vi khuẩn kháng thuốc
(TAP) - Tổ chức Y tế Thế giới (WHO) vừa đưa ra cảnh báo về tốc độ lây lan đáng lo ngại của các siêu vi khuẩn kháng thuốc. WHO quan ngại, diễn biến này trở thành một trong những mối đe dọa sức khỏe nghiêm trọng nhất đối với nhân loại.

Số ca ung thư tiểu thuỳ xâm lấn: Tăng nhanh gấp ba lần so với loại ung thư vú khác
(TAP) - Báo cáo mới từ Hiệp hội Ung thư Hoa Kỳ (ACS) cho thấy, ung thư tiểu thùy xâm lấn - loại ung thư vú khó phát hiện chiếm hơn 10% tổng số ca tại Hoa Kỳ. Ghi nhận dạng bệnh ác tính này tăng nhanh khoảng 3% mỗi năm, cao gấp ba lần so với những loại ung thư vú khác.

Mùa mưa lũ: Cảnh báo nguy cơ bệnh xoắn khuẩn vàng da
(TAP) - Mùa mưa bão không chỉ gây lũ lụt, ngập úng mà còn làm gia tăng nguy cơ mắc nhiều bệnh truyền nhiễm, trong đó có bệnh xoắn khuẩn vàng da (Leptospirosis). Tổ chức Y tế Thế giới (WHO) và các cơ quan y tế Việt Nam cảnh báo rằng bệnh có thể xảy ra tại mọi vùng miền, đặc biệt ở những người phải tiếp xúc trực tiếp với nước lũ hoặc đất nhiễm khuẩn.

WHO cảnh báo tình trạng gia tăng siêu vi khuẩn kháng kháng sinh
(TAP) - Ngày 2/10, Tổ chức Y tế Thế giới (WHO) công bố các báo cáo cho thấy tình trạng gia tăng đáng lo ngại của vi khuẩn kháng kháng sinh trên toàn cầu. Giữa bối cảnh đó, công cụ chẩn đoán và phương pháp điều trị đều không đủ đáp ứng để điều trị tình trạng này.

Sắp mở bán thuốc tiêm ngừa HIV với giá 1 triệu đồng/năm
(TAP) - Tổ chức Y tế quốc tế (Unitaid) vừa công bố kế hoạch phổ biến loại thuốc tiêm lenacapavir - biện pháp phòng ngừa HIV, tại hơn 100 quốc gia trên thế giới, trong đó có Việt Nam. Dự kiến, thuốc sẽ được bán với giá 40 USD mỗi năm (tương đương 1 triệu đồng) kể từ năm 2027.

EU bác bỏ cảnh báo của Trump về mối liên hệ giữa paracetamol và chứng tự kỷ
(TAP) - Cơ quan Dược phẩm Châu Âu (EMA) thuộc EU vừa phản hồi phát ngôn gây tranh cãi của Tổng thống Donald Trump liên quan đến việc sử dụng thuốc giảm đau paracetamol trong thai kỳ có nguy cơ khiến trẻ sau sinh mắc chứng tự kỷ. EMA khẳng định chưa có bằng chứng khoa học nào chứng minh mức độ gây hại như lãnh đạo Nhà Trắng cảnh báo.

Việt Nam: Nhiều ca tử vong do bệnh dại vì chủ quan không tiêm vaccine
(TAP) - Tính riêng 9 tháng đầu năm 2025, Việt Nam ghi nhận 58 ca tử vong do bệnh dại tại 18 tỉnh, thành phố. Đáng chú ý, đa số các trường hợp tử vong đều do không tiêm vaccine hoặc huyết thanh kháng dại. Trong đó, nguyên nhân chính là người dân chủ quan nghĩ rằng chó nhà cắn không nguy hiểm.

Khủng hoảng thiếu thuốc đang kéo dài tại EU
(TAP) - Cuộc khủng hoảng thiếu thuốc đang kéo dài tại Liên minh Châu Âu (EU), với ít nhất 34 loại thuốc khan hiếm. Nguyên nhân chính đến từ sự phân mảnh và thiếu ràng buộc pháp lý trong hệ thống giám sát dược phẩm toàn khối.

Từ năm 2026, người dân được khám sức khỏe miễn phí định kỳ hằng năm
(TAP) – Theo Nghị quyết 72-NQ/TW của Bộ Chính trị Việt Nam, từ năm 2026, toàn dân sẽ khám sức khỏe định kỳ hoặc sàng lọc miễn phí ít nhất mỗi năm một lần. Đến năm 2030, người dân hưởng chính sách miễn viện phí cơ bản trong phạm vi quyền lợi bảo hiểm y tế, hướng tới mục tiêu chăm sóc sức khỏe toàn dân công bằng, bền vững.

Tỷ lệ tử vong ở Hoa Kỳ giảm gần 4% vào năm 2024 nhờ COVID-19?
(TAP) - Theo Trung tâm Kiểm soát và Phòng ngừa Dịch bệnh (CDC), tỷ lệ tử vong chung ở Hoa Kỳ giảm gần 4% vào năm 2024. Sự suy giảm này có liên quan trực tiếp đến việc COVID-19 không còn nằm trong top 10 nguyên nhân gây tử vong hàng đầu kể từ năm 2020.

Bệnh Chagas: Mối nguy hiểm từ “bọ hôn” có dấu hiệu lan rộng tại Hoa Kỳ
(TAP) - Còn được gọi bằng cái tên bệnh “bọ hôn”, Chagas là căn bệnh nguy hiểm do ký sinh trùng gây ra vốn phổ biến tại 21 quốc gia châu Mỹ, nhưng đang có dấu hiệu lan rộng tại Hoa Kỳ.
WHO cảnh báo hai dịch bệnh nguy hiểm
(TAP) - Tổ chức Y tế Thế giới (World Health Organization, viết tắt: WHO) mới đây (ngày 3/9) phát đi cảnh báo toàn cầu về hai dịch bệnh nguy hiểm, bao gồm bệnh chảy máu mắt ở người do virus Marburg và bệnh tả.

Đu đủ - Trái cây quen thuộc sở hữu nhiều lợi ích tuyệt vời cho sức khỏe
(TAP) - Đu đủ không chỉ là loại quả phổ biến, giá rẻ mà còn chứa nhiều dưỡng chất quý giá; giúp cải thiện tiêu hóa, tăng cường miễn dịch, làm đẹp da và hỗ trợ phòng ngừa nhiều bệnh lý nguy hiểm.

Lợi ích sức khỏe từ lá tía tô
(TAP) - Lá tía tô hay tử tô (tên khoa học: Perilla frutescens) là loài cây thân thảo thuộc họ Hoa môi (Lamiaceae), có mùi thơm đặc trưng, vị cay, tính ấm, thường xuyên xuất hiện trong bữa ăn của người Việt. Tuy nhiên, ít ai biết rằng, tía tô còn được ví như một vị thuốc quý mang đến nhiều lợi ích cho sức khỏe con người.

Cải bó xôi – Thực phẩm mang nhiều lợi ích cho sức khỏe
(TAP) - Cải bó xôi hay rau chân vịt (spinach) là một loại rau lá xanh đậm có nguồn gốc từ Ba Tư, được biết đến rộng rãi trên toàn thế giới nhờ hàm lượng dinh dưỡng vượt trội và mang nhiều lợi ích cho sức khỏe.

Đậu bắp – Thực phẩm vàng cho sức khỏe
(TAP) - Đậu bắp là một thực phẩm quen thuộc trong bữa ăn của nhiều gia đình Việt. Không chỉ giàu giá trị dinh dưỡng, loại quả này còn mang lại nhiều lợi ích cho sức khỏe.

Sức khỏe tâm thần: vấn đề cấp thiết cần được quan tâm
(TAP) - Trong bối cảnh hiện đại, sức khỏe tâm thần đang trở thành một vấn đề cấp thiết và nóng hổi. Theo các nghiên cứu, tỷ lệ thanh thiếu niên gặp vấn đề về sức khỏe tâm thần đang gia tăng đáng kể gây ảnh hưởng sâu sắc đến nhiều khía cạnh cuộc sống. Do đó, việc nâng cao nhận thức về sức khỏe tâm thần và tạo ra môi trường cải thiện tình hình là cực kỳ cần thiết.

Bệnh dại: Những điều bạn cần biết để phòng tránh
(TAP) - Nhiều người lầm tưởng rằng chỉ có vết cắn từ chó dại mới dẫn đến nguy cơ mắc bệnh, nhưng trên thực tế, virus này còn có thể lây lan qua những vết liếm hay cào từ động vật nhiễm bệnh. Do đó, việc hiểu rõ về bệnh dại là cực kỳ cần thiết để bảo vệ sức khỏe bản thân và gia đình.

Táo tàu: Công dụng và lợi ích sức khỏe
(TAP) - Táo tàu, một loại quả giàu giá trị dinh dưỡng và có nhiều công dụng trong y học cổ truyền, không chỉ mang đến hương vị thơm ngon mà còn chứa đựng nhiều lợi ích cho sức khỏe. Hãy cùng khám phá những tác dụng nổi bật của loại quả đặc biệt này.

5 thói quen xấu gây hại sức khỏe mà bạn không nhận ra
(TAP) - Nhiều người trong chúng ta có những thói quen tưởng chừng như vô hại hoặc không đáng lo ngại, nhưng thực tế, chúng có thể ảnh hưởng xấu đến sức khỏe lâu dài. Đôi khi, chỉ vì chúng ta không nhận ra mối nguy hiểm tiềm ẩn từ những hành động hàng ngày này. Dưới đây là một số thói quen phổ biến có thể gây hại cho sức khỏe mà bạn cần lưu ý, điều chỉnh để bảo vệ cơ thể.

Khám phá lợi ích tuyệt vời của quả ổi cho sức khỏe
(TAP) - Quả ổi là một loại trái cây rất phổ biến trong đời sống hàng ngày của người dân Việt Nam, mang đến không chỉ hương vị thơm ngon mà còn nhiều giá trị dinh dưỡng tuyệt vời. Hãy cùng tìm hiểu về những lợi ích sức khỏe tuyệt vời mà quả ổi mang lại.

Dịch bệnh Legionnaires bùng phát ở New York, 6 người tử vong, 112 ca nhiễm
(TAP) - Đợt bùng phát dịch bệnh Legionnaires tại khu vực Central Harlem, Thành phố New York (bang New York) tiếp tục diễn biến phức tạp. Theo thông tin từ Sở Y tế địa phương, tính đến ngày 22/8, ghi nhận có 6 người tử vong, 112 ca nhiễm bệnh và 7 trường hợp đang điều trị.

Texas tuyên bố dịch sởi chính thức kết thúc ở địa phương
(TAP) - Mới đây, Sở Dịch vụ Y tế Tiểu bang Texas tuyên bố dịch sởi từng gây lo ngại trên diện rộng chính thức kết thúc ở địa phương này. Tiểu bang không ghi nhận thêm bất kỳ ca bệnh mới nào suốt hơn 42 ngày qua tại những khu vực có dấu hiệu lây lan.

Khuyến cáo về vaccine COVID-19 cho trẻ: AAP và CDC bất đồng quan điểm
(TAP) - Viện Hàn lâm Nhi khoa Hoa Kỳ (AAP) vừa đưa ra hướng dẫn tiêm chủng mới về vaccine COVID-19 cho trẻ em. Tuy nhiên, theo công bố, ghi nhận lần đầu tiên trong 30 năm qua, AAP bất đồng quan điểm trước khuyến cáo từ Chính phủ liên bang, cụ thể là Trung tâm Kiểm soát và Phòng ngừa Dịch bệnh Hoa Kỳ (CDC).

Bắt kịp xu thế, FDA ra mắt công cụ AI để tối ưu hiệu suất phục vụ
(TAP) - Với mục tiêu tối ưu hiệu suất phục vụ trong mọi hoạt động, Cục Quản lý Thực phẩm và Dược phẩm Hoa Kỳ (FDA) vừa ra mắt trí tuệ nhân tạo (AI) tạo sinh mang tên “Elsa”. Đây là công cụ được đánh giá có thể giúp người dân rút ngắn thời gian xin cấp phép thuốc, xử lý nhanh thông tin trên các tờ hướng dẫn sử dụng.

Bộ Y tế Việt Nam cảnh báo Sốt Xuất Huyết, COVID-19 tăng năm 2025
(TAP) - Mới đây, Bộ Y tế Việt Nam cảnh báo khẩn về sự gia tăng sốt xuất huyết, COVID-19 trong năm 2025. Người dân cần đeo khẩu trang, rửa tay thường xuyên để phòng dịch hiệu quả.

Số ca nhiễm COVID-19 tại Thái Lan tăng nhanh vì biến thể XEC
(TAP) - Mới đây, ngành y tế Thái Lan nâng cao mức cảnh báo trước sự bùng phát nhanh chóng của biến thể của COVID-19 mang tên XEC - một hậu duệ của biến thể Omicron.

FDA siết chặt tiêu chuẩn phê duyệt vaccine COVID-19 cho người khỏe mạnh
(TAP) - Cục Quản lý Thực phẩm và Dược phẩm Hoa Kỳ (FDA) vừa điều chỉnh quy trình phê duyệt các mũi tiêm tăng cường vaccine COVID-19, với các tiêu chuẩn nghiêm ngặt hơn đối với người khỏe mạnh. Động thái này đánh dấu sự thay đổi đáng kể trong cách tiếp cận chính sách tiêm chủng của Hoa Kỳ, đồng thời có thể ảnh hưởng đến khả năng tiếp cận vaccine hàng năm của hàng triệu người.

Cục Quản lý Thực phẩm và Dược phẩm Hoa kỳ phê duyệt xét nghiệm HPV tại nhà
(TAP) - Ngày 9/5, Cục Quản lý Thực phẩm và Dược phẩm Hoa Kỳ (FDA) đã chính thức phê duyệt xét nghiệm HPV tại nhà. Động thái đánh dấu bước tiến quan trọng trong việc cải thiện khả năng tiếp cận tầm soát ung thư cổ tử cung cho phụ nữ.

Việt Nam công bố 21 loại thuốc bị làm giả
(TAP) - Liên quan đến vụ án sản xuất, buôn bán thuốc tân dược giả với quy mô lớn lan rộng trên khắp lãnh thổ Việt Nam do Công an tỉnh Thanh Hóa triệt phá, Cục Quản lý Dược (Bộ Y tế Việt Nam) đã có Công văn số 113/QLD-CL công bố danh sách đầy đủ 21 loại thuốc bị làm giả. Vụ việc một lần nữa gióng lên hồi chuông cảnh báo về sự tinh vi ngày càng cao của các loại thuốc giả đang âm thầm len lỏi vào thị trường, đe dọa nghiêm trọng đến sức khỏe cộng đồng.

Táo tàu: Công dụng và lợi ích sức khỏe
(TAP) - Táo tàu, một loại quả giàu giá trị dinh dưỡng và có nhiều công dụng trong y học cổ truyền, không chỉ mang đến hương vị thơm ngon mà còn chứa đựng nhiều lợi ích cho sức khỏe. Hãy cùng khám phá những tác dụng nổi bật của loại quả đặc biệt này.

5 thói quen xấu gây hại sức khỏe mà bạn không nhận ra
(TAP) - Nhiều người trong chúng ta có những thói quen tưởng chừng như vô hại hoặc không đáng lo ngại, nhưng thực tế, chúng có thể ảnh hưởng xấu đến sức khỏe lâu dài. Đôi khi, chỉ vì chúng ta không nhận ra mối nguy hiểm tiềm ẩn từ những hành động hàng ngày này. Dưới đây là một số thói quen phổ biến có thể gây hại cho sức khỏe mà bạn cần lưu ý, điều chỉnh để bảo vệ cơ thể.

Cảnh báo nguy cơ ngộ độc botulinum từ thực phẩm
(TAP) - Ngộ độc botulinum (còn gọi là ngộ độc thịt) là một trong những dạng ngộ độc nguy hiểm nhất, có thể gây tử vong nếu không được phát hiện và điều trị kịp thời.

Bùng phát bệnh sởi tại châu Âu: WHO, UNICEF phát cảnh báo
(TAP) - Tại cuộc họp ở Geneva, Thụy Sĩ vào ngày 14/3/2025, Tổ chức Y tế Thế giới (WHO) và Quỹ Nhi đồng Liên Hợp Quốc (UNICEF) báo động về sự gia tăng đáng lo ngại của bệnh sởi tại khu vực châu Âu.

Dịch sởi bùng phát mạnh, Bộ Y tế Việt Nam họp khẩn
(TAP) - Trước tình hình bệnh sởi diễn biến phức tạp với số ca mắc tiếp tục ở mức cao và nguy cơ gia tăng vào thời gian tới, Bộ Y tế Việt Nam tổ chức cuộc họp khẩn vào ngày 15/3 tại Hà Nội nhằm đề ra các biện pháp phòng, chống hiệu quả.

Việt Nam: Vaccine Rota sẽ được triển khai miễn phí trên toàn quốc
(TAP) - Theo thông tin từ Cổng thông tin Chính phủ Việt Nam, Vaccine Rota phòng tiêu chảy cấp sẽ được triển khai miễn phí tại các cơ sở y tế trên toàn Việt Nam trong Chương trình Tiêm chủng mở rộng. Như vậy, cha mẹ, người chăm sóc trẻ có thể đưa trẻ đến các trạm y tế để được uống vaccine.

Cảnh báo nguy cơ dịch bệnh gia tăng trong mùa nồm ẩm
(TAP) - Mùa xuân miền Bắc với đặc trưng nồm ẩm, mưa phùn kéo dài kết hợp cùng các hoạt động lễ hội đầu năm thu hút đông người tạo điều kiện thuận lợi cho sự phát triển của nhiều loại virus gây bệnh đường hô hấp. Những nhóm đối tượng như người cao tuổi, trẻ em, người mắc bệnh nền, người có hệ miễn dịch suy giảm cần cẩn trọng trước nguy cơ nhiễm cúm và các bệnh truyền nhiễm khác.

Những trường hợp nào không nên uống rượu để tránh tổn thương gan?
(TAP) - Các nhà khoa học cảnh báo, người có vòng bụng to, mặc bệnh tiểu đường hoặc huyết áp cao có nguy cơ tăng gấp đôi tổn thương gan khi uống rượu. Không chỉ gây hại gan, nhiều nghiên cứu còn cho thấy, rượu là nguyên nhân gây ra gần 100.000 trường hợp ung thư ở Hoa Kỳ.

Cảnh báo lạm dụng Tamiflu trong điều trị cúm mùa
(TAP) - Mùa đông xuân là thời điểm bệnh cúm mùa gia tăng mạnh mẽ, đặc biệt là sau Tết Nguyên Đán, khi nhu cầu giao thương, du lịch và tụ tập đông người tăng cao. Trong bối cảnh này, một vấn đề đáng lo ngại đã nảy sinh: nhiều người dân tự ý mua thuốc Tamiflu để điều trị cúm tại nhà mà không có sự hướng dẫn của bác sĩ. Các chuyên gia y tế cảnh báo về nguy cơ lạm dụng thuốc và những hậu quả nghiêm trọng đối với sức khỏe cộng đồng.

Cúm mùa: Hiểm họa tiềm ẩn cần đặc biệt chú ý
(TAP) - Cúm mùa là một bệnh nhiễm trùng đường hô hấp cấp tính do virus cúm (Influenza virus) thuộc họ Orthomyxoviridae gây ra. Theo Tổ chức Y tế Thế giới (WHO), cúm mùa lưu hành trên toàn cầu, lây lan nhanh qua đường hô hấp, giọt bắn khi nói chuyện, hắt hơi hoặc qua tiếp xúc với bề mặt có virus. Đáng chú ý, virus có thể lây từ người bệnh ngay cả trước khi triệu chứng xuất hiện một ngày.

Khám phá lợi ích tuyệt vời của quả ổi cho sức khỏe
(TAP) - Quả ổi là một loại trái cây rất phổ biến trong đời sống hàng ngày của người dân Việt Nam, mang đến không chỉ hương vị thơm ngon mà còn nhiều giá trị dinh dưỡng tuyệt vời. Hãy cùng tìm hiểu về những lợi ích sức khỏe tuyệt vời mà quả ổi mang lại.

Việt Nam: Bộ Y tế muốn phạt nặng người dùng thuốc lá điện tử
(TAP) - Trước thực trạng thuốc lá điện tử và thuốc lá nung nóng lan rộng trong giới trẻ, đe dọa sức khỏe cộng đồng, Bộ Y tế Việt Nam đề xuất phạt tiền người sử dụng lên đến 2.000.000 đồng.

Bụi mịn – hiểm hoạn vô hình tàn phá sức khỏe con người
(TAP) - Trong suốt những năm qua, ô nhiễm không khí đã trở thành một vấn đề toàn cầu cấp bách, không phải do sự ầm ĩ hay sự hiện diện rõ rệt của nó, mà bởi những kẻ vô hình đang dần tàn phá sức khỏe hàng tỷ người - bụi mịn. Liệu chúng ta có đủ nhận thức để đối mặt với mối đe dọa âm thầm nhưng vô cùng nguy hiểm này?

Việt Nam cảnh giác trước dịch bệnh viêm phổi HMPV từ Trung Quốc
(TAP) - Chiều ngày 05/1, Bộ Y tế Việt Nam chính thức cung cấp thông tin về dịch bệnh viêm phổi do virus human metapneumovirus (HMPV) đang được đề cập tại Trung Quốc.

Nguyên nhân nào khiến người trung niên dễ tăng cân?
(TAP) - Tuổi trung niên là một giai đoạn quan trọng trong cuộc đời, nơi con người tích lũy nhiều kinh nghiệm, thành tựu đồng thời đối mặt với những thay đổi lớn lao. Bên cạnh những niềm vui, thử thách, không ít người phải đối diện với một vấn đề thường xuyên gây phiền toái: tăng cân. Hiện tượng này không chỉ ảnh hưởng đến ngoại hình mà còn tiềm ẩn nhiều nguy cơ sức khỏe đáng lo ngại. Vậy nguyên nhân nào khiến người trung niên dễ tăng cân và làm thế nào để kiểm soát hiệu quả vấn đề này?

Dự báo năm 2025, dịch bệnh vẫn phát triển phức tạp
(TAP) - Vào năm 2025, tình hình dịch bệnh toàn cầu tiếp tục phát triển phức tạp, với những nguy cơ từ các bệnh truyền nhiễm mới, đặc biệt là các bệnh lây từ động vật sang người, tiềm ẩn nhiều rủi ro.

Ngộ độc rượu – Nguy cơ đe dọa sức khỏe và tính mạng
(TAP) - Theo thông tin từ Cục An toàn thực phẩm - Bộ Y tế Việt Nam, trong thời gian gần đây, số lượng trường hợp ngộ độc rượu gia tăng đáng kể, dẫn đến nhiều ca phải nhập viện cấp cứu và thậm chí tử vong. Đây là vấn đề nghiêm trọng cần được cộng đồng quan tâm và có biện pháp ngăn chặn kịp thời.

Ô nhiễm không khí: nguy cơ tiềm ẩn với sức khỏe tâm thần
(TAP) - Các nhà nghiên cứu từ Đại học St Andrews (Vương quốc Anh) vừa công bố một nghiên cứu quy mô lớn, tiết lộ mối liên hệ đáng lo ngại giữa ô nhiễm không khí và tỷ lệ nhập viện vì các bệnh tâm thần. Đây là nghiên cứu được đánh giá toàn diện nhất trong lĩnh vực này tính đến thời điểm hiện tại.

Nga chuẩn bị công bố vaccine điều trị ung thư vào năm 2025
(TAP) - Vào ngày 15/12 (giờ địa phương), giới truyền thông Nga đồng loạt đưa tin về bước tiến quan trọng trong lĩnh vực y học tại nước này. Theo đó, Bộ Y tế Nga dự kiến công bố vaccine điều trị ung thư EnteroMix và tiến hành thử nghiệm lâm sàng vào đầu năm 2025, mở ra một hướng đi mới trong việc chữa trị cho những bệnh nhân.

Nguy cơ dịch bệnh Congo: Cộng đồng quốc tế đẩy mạnh phòng chống
(TAP) - Trước tình hình dịch bệnh bí ẩn bùng phát tại Congo, nhiều quốc gia tăng cường kiểm soát tại sân bây và phát đi cảnh báo khuyến cáo người dân.

Việt Nam cấm thuốc lá điện tử, các loại khí, chất gây nghiện từ năm 2025
(TAP) - Quốc hội Việt Nam vừa thống nhất thông qua luật cấm sử dụng thuốc lá điện tử, các loại khí, chất gây nghiện áp dụng từ năm 2025. Bên cạnh đó, việc sản xuất, kinh doanh, nhập khẩu, chứa chấp, vận chuyển nhóm mặt hàng này cũng bị liệt vào hành vi vi phạm pháp luật.

Kiến ba khoang có độc tố mạnh gấp 12 – 15 lần nọc rắn hổ
(TAP) - Kiến ba khoang, còn được gọi là kiến khoang, kiến kim hay kiến lác, là một loài côn trùng có chứa độc tố cực kỳ mạnh. Độc tố Pederin trong loài kiến này mạnh gấp 12-15 lần so với nọc rắn hổ. Tuy nhiên, vì độc tố này chỉ xâm nhập vào cơ thể qua da, với lượng nhỏ nên không đủ gây tử vong nhưng đủ sức gây bỏng rát, viêm nhiễm nếu tiếp xúc với da. Vì vậy, việc phòng tránh tiếp xúc với loài kiến này là rất cần thiết để bảo vệ sức khỏe.

Nguy cơ sức khỏe tâm lý từ mạng xã hội: Cảnh giác kẻo muộn!
(TAP) - Trong xã hội hiện đại, sự phát triển mạnh mẽ của công nghệ thông tin và mạng xã hội đã tác động sâu rộng đến mọi mặt trong đời sống con người. Dễ dàng nhận thấy, công nghệ mang lại nhiều tiện ích, giúp con người kết nối nhanh chóng, chia sẻ thông tin và nâng cao hiệu quả công việc. Tuy nhiên, bên cạnh những mặt tích cực, không thể phủ nhận rằng công nghệ, đặc biệt là mạng xã hội, cũng đang dần trở thành một tác nhân gây hại cho sức khỏe tâm lý của con người. Những tác động tiêu cực này ngày càng trở nên rõ rệt và đáng lo ngại.

Thuốc lá điện tử không phải phương pháp cai thuốc lá hiệu quả
(TAP) - Thuốc lá điện tử, thuốc lá nung nóng không phải phương pháp hỗ trợ cai thuốc lá hiệu quả. Thực tế, thanh thiếu niên sử dụng thuốc lá điện tử có khả năng bắt đầu hút thuốc lá thông thường cao gấp ba lần so với những người không sử dụng.

Bệnh dại: Những điều bạn cần biết để phòng tránh
(TAP) - Nhiều người lầm tưởng rằng chỉ có vết cắn từ chó dại mới dẫn đến nguy cơ mắc bệnh, nhưng trên thực tế, virus này còn có thể lây lan qua những vết liếm hay cào từ động vật nhiễm bệnh. Do đó, việc hiểu rõ về bệnh dại là cực kỳ cần thiết để bảo vệ sức khỏe bản thân và gia đình.

Bộ Y tế Việt Nam chỉ đạo khẩn trước dịch bệnh Marburg
(TAP) - Cục Y tế dự phòng - Bộ Y tế Việt Nam vừa phát đi văn bản chỉ đạo triển khai các biện pháp, tăng cường giám sát người nhập nhập cảnh nhằm kiểm soát dịch bệnh Marburg. Đây là một căn bệnh có khả năng lây truyền và tỷ lệ tử vong cao lên đến 88%.

Bí quyết duy trì sự minh mẫn của những người sống thọ
(TAP) - Cuộc sống trường thọ không chỉ là sống lâu, mà còn phải sống khỏe mạnh và tràn đầy năng lượng. Người sống thọ nhưng vẫn duy trì sự minh mẫn thường có lối sinh hoạt và thói quen rất cụ thể. Hãy khám phá bí quyết của những người sống thọ để cùng tận hưởng hành trình này.

Các lợi ích sức khỏe từ quả bơ
(TAP) - Bơ là một trái cây phổ biến có giá trị dinh dưỡng cao gồm hơn 20 loại vitamin, chất xơ, chất béo và khoáng chất kali, lutein, folate. Chính vì thế, loại quả này được xem như một siêu thực phẩm mang lại nhiều lợi ích sức khỏe.

5 lý do cho thấy giấc ngủ rất quan trọng
(TAP) - Ngoài việc ăn uống lành mạnh và tập thể dục thường xuyên, ngủ đủ giấc cũng là một trong các yếu tố quan trọng mà mọi người cần chú ý để duy trì sức khỏe bền vững. Vậy tại sao một giấc ngủ ngon và chất lượng lại quan trọng đến thế?

Một số bệnh có nguy cơ bùng phát trong mùa mưa bão
(TAP) - Cơn bão số 3 (Yagi) đi qua đã gây không ít thiệt hại về tính mạng và tài sản của người dân. Không dừng lại ở đó, sau mùa mưa bão, nguy cơ bùng phát dịch bênh khá cao khi môi trường trở nên ô nhiễm, ẩm thấp, tích tụ vi khuẩn, bụi rác, chất thải, …Chính vì thế người dân nên chú ý đề phòng một số bệnh có thể xảy trong mùa mưa bão để hạn chế tối đa bị lây nhiễm.

Doanh nghiệp Nhật Bản phải báo cáo ảnh hưởng từ thực phẩm chức năng
(TAP) - Bắt đầu từ ngày 01/09, các doanh nghiệp Nhật Bản phải báo cáo cụ thể những ảnh hưởng sức khỏe từ chất bổ sung, sản phẩm dán nhãn “có lợi cho sức khỏe” và “thực phẩm bổ sung” cho cơ quan chức năng.

Việt Nam: Tăng cường các biện pháp phòng, chống và kiểm soát dịch bệnh sởi
(TAP) - Tình hình dịch bệnh sởi có nguy cơ bùng phát tại Việt Nam, để đảm bảo vắc xin sởi luôn sẵn có, Bộ Y tế Việt Nam đã chủ động phối hợp với các đơn vị liên quan để sử dụng ngân sách trung ương mua sắm vắc xin và nhận viện trợ từ Chính phủ Úc.

Một số công dụng tốt cho sức khỏe của ớt chuông
(TAP) - Ớt chuông (bell peper) là một loại quả mọng dày thịt, nhiều hạt, có nguồn gốc từ vùng Trung, Nam Mĩ. Loại quả này có thể ăn sống hoặc nấu cùng với các loại thực phẩm khác để tăng thêm màu sắc và hương vị cho các món ăn. Nhờ chứa hàm lượng dinh dưỡng cao, việc bổ sung ớt chuông vào bữa ăn có thể mang lại nhiều công dụng tốt cho sức khỏe.

Bộ Y tế Việt Nam triển khai thêm 4 vaccine miễn phí
(TAP) - Bộ Y tế Việt Nam sẽ triển khai thêm 4 vaccine miễn phí vào chương trình “Tiêm chủng mở rộng”, nhằm tăng cơ hội phòng bệnh cho người dân. Trong đó bao gồm vaccine ngăn ngừa ung thư cổ tử cung, vaccine phòng cúm mùa, vaccine phòng bệnh do virus Rota và vaccine phòng bệnh do phế cầu.

Phụ nữ mang thai được khuyến cáo tiêm vắc xin phòng bệnh ho gà
(TAP) - Bộ Y tế Việt Nam khuyến cáo phụ nữ mang thai trong kỳ thứ 3 (khoảng tuần thai từ 27 đến 36) tiêm vắc xin phòng ho gà giúp bảo vệ người mẹ khỏi nhiễm bệnh, cung cấp khả năng miễn dịch thụ động cho trẻ sơ sinh.

Dấu hiệu và triệu chứng của bệnh đậu mùa khỉ
(TAP) - Đậu mùa khỉ là một bệnh truyền nhiễm vô cùng nguy hiểm đối với sức khỏe con người. Đặc biệt là khi thời gian vừa qua, vào ngày 14/08, Tổ chức Y tế Thế giới (WHO) đưa ra cảnh báo tình trạng khẩn cấp toàn cầu với bệnh nhiễm trùng từ virus đậu mùa khỉ. Thế nên, việc tìm hiểu nhận biết sớm các dấu hiệu và triệu chứng của bệnh đậu mùa khỉ là vô cùng cần thiết để phòng ngừa và điều trị kịp thời.

Cần tăng cường bảo vệ trẻ em trước bệnh sởi
Ngày 15/08, Bộ Y tế Việt Nam khuyến cáo các phụ huynh tăng cường biện pháp bảo vệ trẻ em trước bệnh sởi - một bệnh truyền nhiễm vô cùng nguy hiểm.

WHO: Cảnh báo tình trạng khẩn cấp toàn cầu với bệnh nhiễm trùng do virus đậu mùa khỉ
(TAP) - Mới đây, Tổng giám đốc Tổ chức Y tế Thế giới đã tuyên bố đợt bùng phát bệnh mpox (bệnh nhiễm trùng gây ra do virus đậu mùa khỉ) ở Châu Phi là tình trạng khẩn cấp về sức khỏe toàn cầu.

Hoa Kỳ: Thu hồi hàng loại sản phẩm kem đóng hộp vì nguy cơ gây ngộ độc, tử vong
(TAP) - Nếu đang sở hữu một trong những sản phẩm kem đóng hộp này trong nhà (danh sách bên dưới), công dân nên lập tức tiêu hủy, gửi sản phẩm về nơi sản xuất hoặc điểm bán để được hoàn tiền. Nếu bất chấp sử dụng các sản phẩm bị khuyến cáo, người dùng sẽ có nguy cơ gây ngộ độc hoặc thậm chí tử vong

Nevada: Muỗi mang virus West Nile tăng đáng kể ở thung lũng Las Vegas, địa phương lên tiếng cảnh báo
(TAP) - Các quan chức y tế Las Vegas (bang Nevada) cho biết, quá trình lây lan của Virus “West Nile” qua muỗi vằn tăng mạnh suốt thời gian qua. Trong bối cảnh nhiều trường hợp nhiễm bệnh có thể chuyển nặng, thậm chí tử vong, địa phương đã lên tiếng cảnh báo, hướng dẫn công dân một số biện pháp phòng ngừa, giữ an toàn cho bản thân và gia đình.

Vì sao trước khi ngủ nên đọc sách?
(TAP) - Giữa nhịp sống hối hả và bận rộn, nhiều người tìm đến giấc ngủ như một liều thuốc cho tinh thần và thể chất. Tuy nhiên, để có một giấc ngủ ngon và trọn vẹn, không chỉ đơn giản là chìm vào giấc ngủ mà còn cần sự chuẩn bị kỹ lưỡng. Và một trong những bí quyết đơn giản nhưng hiệu quả chính là thói quen đọc sách trước khi ngủ.

Những công dụng bất ngờ từ nước chanh mật ong
(TAP) - Theo nhiều nghiên cứu, chanh và mật ong kết hợp có thể mang lại nhiều lợi ích cho sức khỏe. Khi bạn uống nước chanh mật ong hàng ngày sẽ thấy được những thay đổi bất ngờ.

Hoa Kỳ: Thêm sản phẩm bị thu hồi vì nghi chứa vi khuẩn E. coli
(TAP) - Dịch vụ Kiểm tra An toàn Thực phẩm (Food Safety and Inspection Service, viết tắt: FSIS) thuộc Bộ Nông nghiệp (Department of Agriculture) cho biết, lượng lớn thịt bò xay tươi (sống) vừa bị thu hồi vì nghi nhiễm nhiễm E. coli O157:H7 (gọi tắt E. coli). Đáng nói rằng đây không phải lần duy nhất trong vòng 7 ngày qua có sản phẩm bị thu hồi liên quan đến vi khuẩn gây bệnh truyền nhiễm.

California - Washington: Thu hồi sản phẩm có chứa vi khuẩn E. coli gây tử vong
(TAP) - Trang trại Gibson (Gibson Farms) vừa thông báo thu hồi quả óc chó (dạng miếng hoặc nửa miếng) được bán cho các nhà phân phối ở bang California và Washington. Tuyên bố trên xuất hiện sau khi có thông tin cho rằng sản phẩm từ nông trại này chứa vi khuẩn E. Coli 0157:H7. E. coli O157:H7 (viết tắt E. coli) gây bệnh truyền nhiễm.

Hoa Kỳ: Đảm bảo quyền lợi cho nhân viên chăm sóc y tế tại nhà
(TAP) - Phó Tổng Thống Hoa Kỳ Kamala Harris vừa thông tin về những kết quả đạt được trong việc cải thiện khả năng tiếp cận dịch vụ và hỗ trợ người dân cần chăm sóc. Đồng thời, bà Harris cũng công bố một quy tắc mới vừa hoàn thiện, giúp cải thiện khả năng tiếp cận các dịch vụ chăm sóc tại nhà cũng như cải thiện chất lượng công việc chăm sóc về chăm sóc tại gia.

California (Hoa Kỳ): Xuất hiện muỗi vằn gây bệnh ở Quận Santa Clara
(TAP) - Aedes aegypti - loài muỗi vằn gây bệnh truyền nhiễm sốt xuất huyết và sốt da vàng, vừa được phát hiện tại khu dân cư ở Đông San José (Quận Santa Clara, bang California). Trước nguy cơ bùng phát đợt xấm lấn, chính quyền địa phương đã kêu gọi cộng đồng chú ý và chung tay tiêu diệt loài gây hại.

Hoa Kỳ: Thu hồi hàng triệu túi bột giặt gây nguy hại sức khỏe
(TAP) - Gần 8,2 triệu túi bặt giặt thương hiệu Tide, Gain, Ace và Ariel phân phối ở thị trường Hoa Kỳ vừa bị Ủy ban An toàn Sản phẩm Tiêu dùng (Consumer Product Safety Commission, viết tắt: CPSC) và Procter & Gamble (P&G) - tập đoàn tiêu dùng đa quốc gia có trụ sở tại Ohio đưa ra tuyên bố thu hồi.

California (Hoa Kỳ): Cảnh báo nguy cơ nhiễm chì từ sản phẩm kem trị trĩ
(TAP) - Sau vụ người phụ nữ ở Sacramento tử vong do nhiễm chì vì bôi thuốc trị trĩ không rõ nguồn gốc có tên “Cao Boi Tri Cay Thau Dau”, Sở Y tế Công cộng California (California Department of Public Health, viết tắt: CDPH) đã ban hành lệnh thu hồi sản phẩm.

Hoa Kỳ: Mở rộng khả năng tiếp cận y tế trên toàn thế giới
Kể từ sau thảm họa COVID-19, cùng với việc đẩy mạnh đầu tư nhằm chuẩn bị tốt hơn cho những đại dịch tiếp theo, Hoa Kỳ đang hỗ trợ các nước trên thế giới mở rộng khả năng tiếp cận biện pháp ứng phó trong lĩnh vực y tế.

Tác hại của việc thức khuya thường xuyên
Theo nhịp sống hiện đại đầy bận rộn, nhiều người thường duy trì thói quen thức khuya dù biết đây là một thói quen không tốt cho sức khỏe. Thức khuya thường xuyên không chỉ khiến cơ thể mệt mỏi, cạn kiệt năng lượng, suy giảm sức đề kháng mà còn tiềm ẩn những tác hại khôn lường đối với sức khỏe.

CDC Hoa Kỳ khuyến khích tiêm chủng nirsevimab ngăn ngừa RSV cho trẻ
Nghiên cứu mới đây của các chuyên gia y tế cho thấy, kháng thể nirsevimab có tác dụng kéo dài và bảo vệ trẻ sơ sinh khỏi nhập viện do virus hợp bào hô hấp (Respiratory Syncytial Virus Infection, viết tắt: RSV).

Những lợi ích tuyệt vời của cà phê đối với sức khỏe
Cà phê là loại thức uống quen thuộc được nhiều người ưu chuộng, với nhiều loại khác nhau cùng cách pha chế cũng vô cùng đa dạng, hấp dẫn. Ngoài việc giúp tinh thần trở nên tỉnh táo hơn, cà phê còn đem đến những lợi ích tuyệt vời cho sức khỏe.

Hoa Kỳ: Tìm thấy chất gây ung thư trong sản phẩm trị mụn
Cục quản lý Thực phẩm và Dược phẩm (Food and Drug Administration, viết tắt: FDA) Hoa Kỳ vừa nhận được đơn đề nghị thu hồi một số sản phẩm trị mụn thương hiệu Clearasil, Proactiv, Clinique,… Nguyên nhân vì chúng chứa nhiều benzoyl peroxide - hàm lượng hóa chất có nguy cơ gây ung thư.









